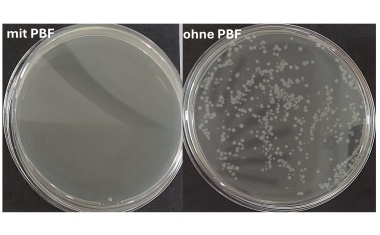
Photo

Nachhaltigkeit in der Krankenhaushygiene
Die Krankenhaushygiene schützt vor nosokomialen Infektionen. Gleichzeitig verursacht sie ökologische und ökonomische Effekte.

Die Krankenhaushygiene schützt vor nosokomialen Infektionen. Gleichzeitig verursacht sie ökologische und ökonomische Effekte.

Nachhaltigkeit ist ein integraler Bestandteil von Tork. Tork engagiert sich dafür, das Leben in öffentlichen und professionellen Umgebungen nachhaltiger zu gestalten.

Tork Vision Reinigung bietet eine fortschrittliche Lösung, um Reinigungsergebnisse zu optimieren, eine konstant hohe Qualität zu gewährleisten und Arbeitsabläufe effizienter zu gestalten.

Tork hat ein innovatives VR-Händehygienetraining entwickelt, das medizinisches Fachpersonal dazu befähigt die Händehygiene sowie die Reinigung der Umgebung zu optimieren.

Nosokomiale Infektionen stellen für Krankenhäuser und andere Gesundheitseinrichtungen eine komplexe und vielschichtige Herausforderung dar.

Wissenschaftler der Universität Basel haben festgestellt, dass bestimmte Bakterien ihre Konkurrenten mit einem molekularen Harpunensystem angreifen. Bakterienstämme, die Schutzmechanismen gegen diese Angriffe entwickeln, zeigen dabei eine erhöhte Empfindlichkeit gegenüber Antibiotika.

Wenn im Praxisalltag eine Aufgabe die nächste jagt und Patient:in auf Patient:in folgt, braucht es beim Thema Hygiene einen starken Partner an der Seite.

Kleine Unterbrechung, große Wirkung: Warum die 30 Sekunden zwischen zwei Patienten die wichtigste halbe Minute des Tages sein kann.

Forscher der Universitätsmedizin Oldenburg haben ein KI-Modell entwickelt, das zuverlässiger als andere Methoden antibiotikaresistente Bakterien identifizieren kann, weil es deutlich weniger falsch-positive Ergebnisse produziert.

Potenziell gefährliche Staphylokokken konkurrieren in der menschlichen Nasenhöhle mit anderen Bakterien um Biotin. Das könnte neuer Ansatzpunkt im Kampf gegen die Keime sein.

Forscher am HZI, HIRI und HIOH erkunden molekulare Mechanismen und das therapeutische Potenzial von Bakteriophagen.

Weltweit hat knapp ein Drittel der Frauen in der fruchtbaren Lebensphase eine bakterielle Vaginose. Dabei kommt das empfindliche Mikrobiom der Vagina aus dem Gleichgewicht.

Die Deutsche Krankenhausgesellschaft (DKG) warnt eindringlich vor den Folgen des laufenden Biozid-Verfahrens der Europäischen Union, das dazu führen könnte, dass Ethanol als Wirkstoff in Hand- und Flächendesinfektionsmitteln faktisch nicht mehr eingesetzt werden darf.

Wiederkehrende Hygienemängel systematisch erfassen und beheben

Forschende entwickeln Methoden, um das Pandemiepotenzial neuer Viren frühzeitig zu erkennen.

Die Bekämpfung der einstigen Lästlinge, heute mit humanmedizinischer Relevanz, verlangt nach einem ökologisch sinnvollen Umweltmanagement.

Eine HZI-Studie an einer digitaler Kohorte zeigt Unterschiede zwischen dokumentierter und selbstberichteter Polioimpfquote.

Atemschutzmasken sind aus dem Alltag nicht mehr wegzudenken. Ob im Gesundheitswesen, im industriellen Arbeitsschutz oder während globaler Pandemien – sie schützen vor Schadstoffen und Krankheitserregern.

Polypeptidantibiotika auf niedrigstem Wert seit 2011, leichter Anstieg bei Fluorchinolonen und Cephalosporinen der 3. und 4. Generation

In Gesundheitsdienst und Wohlfahrtspflege sind Desinfektionsmittel zur Infektionsprävention unverzichtbar.
Das Fraunhofer FEP untersucht plasmaaktiviertes Wasser als chemikalienfreie Alternative zu herkömmlichen Desinfektionsmitteln.

Welchen Einfluss hat die Wassertemperatur, die Waschdauer und die Wassermenge auf das Händewaschen? Zwei Studien der Medizinischen Universität Wien zeigen überraschende Ergebnisse.

Das Schwerpunktkrankenhaus im Innviertel setzt seit Kurzem auf neueste Technik bei der Händehygiene und sorgt im Eingangsbereich des Mitarbeiter-Restaurants für einen Hingucker.

Diagnostic Stewardship sollte in die Arbeit der Hygieneteams auf allen Ebenen der Patientenversorgung und im Bereich der Umgebungsuntersuchungen integriert werden.

Die Anforderungen an Hygieneprodukte und Infektionsprävention in Einrichtungen des Gesundheitswesens steigen kontinuierlich.

Der nächste Meilenstein des Projekts ist erreicht.

Licht an – Bakterien tot. So einfach könnte das Desinfizieren von Oberflächen sein.

HIOH-Forscherin Katharina Schaufler spricht im Interview über antibiotikaresistente Keime im Ostseewasser und den dringenden Handlungsbedarf.

ERC Starting Grant geht an Jens Hör vom Helmholtz-Institut für RNA-basierte Infektionsforschung.

In Kliniken ist eine zuverlässige Trinkwasserversorgung wichtig. Leitungsgebundene Wasserspender bieten eine Lösung. Natürlich muss die Hygiene stimmen.

Herbstaktion: zwei Wäschereimaschinen kaufen – und mehrfach sparen

Fraunhofer-Forscher entwickeln innovative Diagnostik zur Erkennung von Antibiotika-Resistenzen bei bakterieller Infektion

Wie viel Zeit benötigt eine voll wirksame, sporizide Desinfektion? Mit Sporosan: Sekunden! Wie funktioniert das?

Da immer mehr Bakterien gegen Antibiotika resistent werden, erforschen Wissenschaftler des KIT neue Ansätze zur Behandlung von Infektionen am Beispiel des Bakteriums Yersinia enterocolitica.

Mehrere hundert Mitarbeitende aus dem Pflegebereich und dem ärztlichen Dienst, zudem auch zahlreiche Patienten und Besucher, besuchten am 28. August im Rahmen des jährlichen Aktionstages für "Saubere Hände" den Stand im Foyer der Zentralklinik.